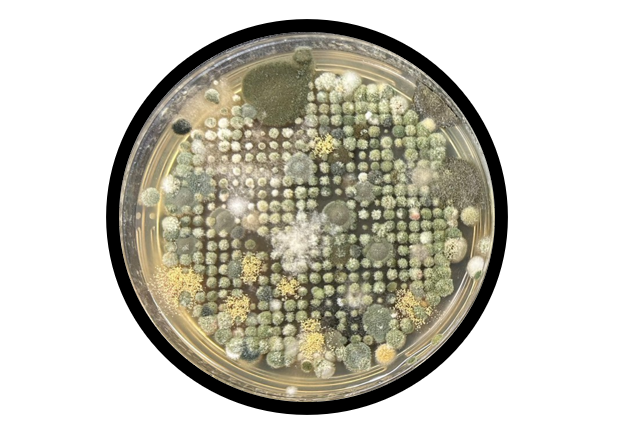
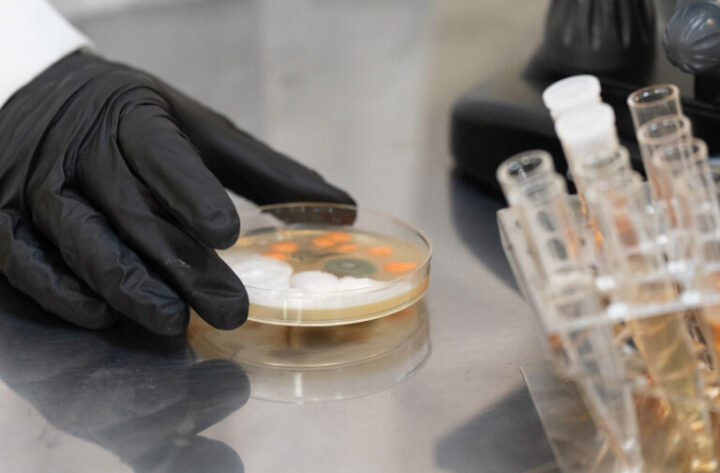

倉庫内で発生したカビの状況を把握するため、ハーツリッチ株式会社(ハーツクリーン事業部)が調査を行いました。
調査では、空気中のカビ量を数値化する浮遊菌検査をはじめ、寒天培地による培養調査、表面に付着した菌を確認する付着菌検査、含水率の測定などを行い、倉庫内の環境を多角的に評価しています。
今回は、その調査内容と結果を、実際の事例としてご紹介します。
1. 倉庫環境に関する調査概要

今回の調査は、倉庫内で確認されたカビ発生の要因を明らかにすることを目的として実施しました。
以下は、実施した調査の概要です。
- 診断目的:カビ発生原因の特定と、倉庫環境の現状把握
- 診断方法:浮遊菌検査、培養調査、付着菌検査、外観目視
- 調査対象:新潟県内の異なる地点に所在する常温の物流倉庫2か所
2. 空気中のカビを数値化する「浮遊菌検査」
倉庫内のカビ汚染状況を把握するため、空気中に含まれるカビの量を測定する「浮遊菌検査」を実施しました。
空気を採取して寒天培地で培養し、一定期間の培養結果から空気中のカビ量を数値として評価します。
2-1. 判定基準(清潔〜汚染の4区分)
浮遊カビ数の汚染度は、次の4区分で評価しています。
| 区分 | 判定基準(CFU/100L) |
|---|---|
| 清潔区域 | 5 以下 |
| 準清潔区域 | 20 以下 |
| 準汚染区域 | 21〜99 |
| 汚染区域 | 100 以上 |
数値が大きいほど、空気中にカビが多く存在している状態と判断します。
2-2. 倉庫の空気環境
調査対象となった2つの倉庫を、ここでは便宜上「倉庫A」「倉庫B」として整理します。
倉庫A

| 測定番号 | ① | ② | ③ | ④ | ⑤ |
|---|---|---|---|---|---|
| CFU/100L | 25 | 39 | 291 | 360 | 359 |
| 測定番号 | ⑥ | ⑦ | ⑧ | ⑨ | ⑩ |
|---|---|---|---|---|---|
| CFU/100L | 124 | 145 | 98 | 51 | 104 |
保管エリア全体が準汚染〜汚染状態に分類される数値でした。
特に外壁に接する区域では含水率が高く、カビ汚染度も高い傾向が確認されました。
倉庫B

| 測定番号 | ① | ② | ③ | ④ | ⑤ |
|---|---|---|---|---|---|
| CFU/100L | 35 | 38 | 63 | 33 | 12 |
| 測定番号 | ⑥ | ⑦ | ⑧ | ⑨ | ⑩ |
|---|---|---|---|---|---|
| CFU/100L | 12 | 15 | 27 | 18 | 23 |
外壁側の区域が準汚染状態にあり、カビが発生しやすい環境となっていました。
商品が保管されていたエリアも準汚染区画に該当しており、カビの増殖リスクが高い状態でした。
2-3. 検出された主なカビの種類
浮遊菌および表面付着菌の培養結果から、主に以下のカビが検出されました。
- クラドスポリウム属
- アスペルギルス属
- ペニシリウム属
一般的に、黒カビ(クラドスポリウム)は湿度の高い環境や結露の生じやすい面に発生しやすく、一方で青カビ(アスペルギルス・ペニシリウム)は木材やプラスチックなど、比較的乾燥した素材に付着しやすいことが知られています。
3. 建物の状態を確認する「含水率測定」と「表面付着菌検査」
倉庫内の湿気の状況や、建物表面に付着したカビ量を把握するため、含水率の測定と付着菌検査を実施しました。
3-1. 含水率測定の結果
倉庫Aと倉庫Bの含水率は以下の通りです。
倉庫A

倉庫B

壁面や構造部材の含水率を確認したところ、一部で水分を多く含む箇所があり、冬場の結露が生じていた可能性があります。
特に外壁側では含水率が高く、カビ汚染度の高い区域と重なっており、このような状態がカビ発生の要因となっていました。
3-2. 付着菌の結果
付着菌検査では、以下の基準で評価を行っています。
| 菌数(100cm²あたり) | 判定 |
|---|---|
| 0〜500 | 清潔 |
| 501〜3,000 | 注意 |
| 3,001〜 | 汚染 |

今回の調査では、57,461 CFU/100cm²という極めて高い付着菌量が検出され、これは清潔値とされる500 CFU/100cm²と比較して100倍以上の数値に相当します。
この高い数値は、付着菌の増殖につながる埃の蓄積に加え、含水率の高さや高湿度といった環境条件が重なった結果であると考えられます。
4. カビ発生につながった環境要因

倉庫内で確認されたカビ発生の背景を整理すると、複数の環境要因が重なっていたことが分かりました。
以下に、調査で明らかになった主な要因をまとめます。
4-1. カビが発生しやすくなる条件
カビは、いくつかの条件がそろうことで急速に増殖しやすくなります。
一般的には次の5要因が揃うと発生リスクが高まります。
- 栄養分(埃・紙類・木材など)
- 酸素(通常の空気環境で十分存在)
- 温度(20〜30℃で特に増えやすい)
- 湿度(相対湿度80%以上、または結露が生じる環境)
- 時間(高湿状態が継続する期間)
これらが揃うと、空気中に存在するカビが付着・発芽しやすくなります。
4-2. 倉庫内で確認されたカビ発生要因
調査の結果、倉庫では次のような条件が重なっていました。
外壁周辺の湿気と結露: 外壁に面した区域で含水率が高く、冬場の結露が見られる状態だった
埃の蓄積: 長期間にわたり埃が溜まっており、カビが増えやすい環境になっていた
季節的な温湿度の高さ: 5月〜10月にかけて温暖・高湿な環境が続いていた
このように、栄養分や湿度が揃った状態が長く続いたことで、倉庫内ではカビが増えやすい環境が形成されていたと考えられます。
5. 梱包内部のカビ発生と保管環境の関係

梱包内部のカビ発生には、倉庫側の環境要因に加えて別の要素が関与していたと考えられます。
商品はクリーンルームで仕上げられた場合でも、完全に無菌というわけではなく、ごく微量のカビが付着していることがあります。
こうした初期付着が残った状態で、温度と湿度の高い環境が長期間続くと、梱包内部でカビが増殖しやすくなります。
6. 倉庫環境を改善するための今後の対策
今回の調査結果から、現在の保管環境はカビの発生を防ぐには不十分であり、環境改善が必要であると判断されました。
今後有効と考えられる対策は以下の通りです。
6-1. 汚染状態のリセット
建物内にすでに存在しているカビを除去するため、専門の除カビ作業によるリセットが必要です。
除カビ後は、再発を防ぐために、定期的な清掃を継続して行うことが大切です。
6-2. 継続的な湿度管理とモニタリング
倉庫内の湿度を把握するため、湿度計を設置して数値を継続的に記録します。
湿度が高くなりやすいエリアでは除湿機を活用し、必要に応じて換気も行うことで、適切な湿度を維持します。
6-3. 結露防止策の実施
含水率が高かった壁面には、断熱材の追加などによる結露防止策が有効です。
特に外壁側の湿気を帯びやすい箇所に対して重点的に対策を施すことで、カビ発生リスクを低減できます。
6-4. カビ繁殖時期における強化策
カビが繁殖しやすい時期には、相対湿度を低く保つために除湿機を積極的に活用します。
さらに、カビ抑制剤の定期散布などを行うことで、商品をより衛生的な状態で保管できます。
7. カビリスクを防ぐための環境調査の重要性
カビは発生すると商品の廃棄やクレーム、ブランド価値の低下につながる可能性があります。
しかし、倉庫内を見回しただけでは、空気中のカビ量や建物内部の湿気、埃に潜むカビまでは把握できません。
浮遊菌検査・表面付着菌検査・含水率測定といった調査により環境を数値化することで、感覚ではなくデータに基づいた的確な判断が可能になります。
倉庫や工場、店舗、宿泊施設などでカビやカビ臭の兆候が見られる場合は、早めに環境調査を行うことでトラブルを未然に防げます。
ハーツリッチ株式会社(ハーツクリーン事業部)では、調査から原因分析、除カビ・防カビ対策まで一貫して対応していますので、ぜひご相談ください。
8. まとめ
今回の調査では、浮遊菌・付着菌・含水率の結果から、保管エリアの一部で準汚染〜汚染レベルのカビが確認されました。
さらに外壁側では含水率の高い状態が見られ、季節によっては高湿度の環境となることもあり、これらがカビの増殖を助長する要因になっていたと考えられます。
こうした複数の条件が重なったことで倉庫内ではカビが発生しやすい状態となり、結果として梱包内部のカビにも影響した可能性があります。
倉庫のカビは商品トラブルや衛生面の問題につながることもあるため、早めの対策が重要です。
カビやカビ臭が気になる状況がある場合は、専門業者によるカビ調査を検討してください。
現状を正しく把握し、適切な対策を講じることで、カビによるリスクを確実に減らすことができるでしょう。

